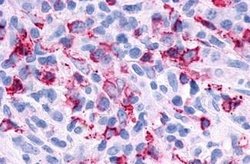
Invitrogen P2Y6 Polyclonal Antibody 25 &mu;g; Unconjugated:Anticuerpos

missing translation for 'onlineSavingsMsg'
Learn More
Learn More
Invitrogen™ P2Y6 Polyclonal Antibody
Rabbit Polyclonal Antibody
Marca: Invitrogen™ PA120617
Este artículo no se puede devolver.
Vea la política de devoluciones
Descripción
PA1-20617 detects P2Y6 in human samples.
P2Y6 belongs to the family of G protein coupled receptors. This family has several receptor subtypes with different pharmacological selectivity, which overlaps in some cases, for various adenosine and uridine nucleotides. This receptor is responsive to UDP, partially responsive to UTP and ADP, and not responsive to ATP. P2Y6 expression has been documented in various blood cells, bone marrow, brain, colon, heart, kidney, ovary, placenta, spleen and thymus. ESTs have been isolated from cervix, embryo, eye, kidney, liver/spleen, placenta, and vessel libraries.
Especificaciones
| P2Y6 | |
| Polyclonal | |
| Unconjugated | |
| P2ry6 | |
| 2010204J23Rik; G-coupled nucleotide receptor; MGC15335; P2 purinoceptor; P2ry6; P2Y ATP receptor 6; P2Y purinoceptor 6; p2y3 and chick; p2y3 receptor; P2Y6; P2Y6 receptor; PP2891; Purinoceptor p2y6; pyrimidinergic receptor P2Y, G-protein coupled, 6; pyrimidinergic receptor P2Y6 | |
| Rabbit | |
| Antigen affinity chromatography | |
| RUO | |
| 100358580, 100512849, 100752781, 117264, 5031, 539703 | |
| Store at 4°C short term. For long term storage, store at -20°C, avoiding freeze/thaw cycles. | |
| Liquid |
| Immunohistochemistry (Paraffin) | |
| 1 mg/mL | |
| PBS with 0.1% sodium azide | |
| Q15077, Q63371 | |
| P2ry6 | |
| Synthetic 17 amino acid peptide from 2nd cytoplasmic domain of human P2RY6/P2Y6. | |
| 25 μg | |
| Primary | |
| Human, Rat, Rabbit, Monkey, Bovine, Hamster, Pig | |
| Antibody | |
| IgG |
Corrección del contenido de un producto
Proporcione sus comentarios sobre el contenido del producto rellenando el siguiente formulario.
Título del producto
¿Detecta una oportunidad de mejora?Comparta una corrección de contenido